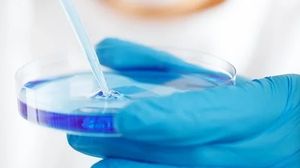
Un medic a încercat să vândă un medicament împotriva coronavirusului Un medic a încercat să vândă un medicament împotriva coronavirusului

kanald.ro

Diverse
Un medic a încercat să vândă un medicament fals împotriva coronavirusului, pe Facebook. Ce preț avea
În timp ce cazurile de coronavirus cresc, la fel se întâmplă și cu informațiile false din mediul online.
Un presupus medic a postat pe pagina lui de Facebook că vinde un medicament împotriva virusului COVID-19. „Tratamentul minune” își face efectul în cinci zile și putea fi cumpărat doar cu 50 de lei.
„Am elaborat formula pentru Picaturi homeopate pentru gripa corona”, așa începea anunțul postat pe rețeaua de socializare de un pretins medic, potrivit Digi24.

Vânzătorul susține că tratamentul se administrează de două ori pe zi, înainte de masă. Dacă simptomele continuă, atunci doza ar trebui mărită.
Citeste si: Rodica, o româncă stabilită în Spania, a luat coronavirus de la o doctoriță: „M-a îmbrățișat și...”
Citeste si: "Faceti sex!"- Sfaturile celebrului Dr Oz pentru cuplurile izolate la domiciliu in epidemie de coronavirus
Medicamentul era promovat de un medic
Alexandru Rafila, președintele Societății Române de Microbiologie, a declarat pentru sursa citată că este vorba de un doctor, iar Colegiul Medicilor ar trebui să ia atitudine.
„Acest medicament minune era promovat de un medic, nu știu cu ce se ocupă, cică ar fi chirug, eu sper că este o eroare, și Colegiul Medicilor ar trebui să aibă o atitudine. El poate să fie general, sau un efect placebo sau nutrițional, dar nu are legătură cu infecția cu coronavirus și dacă se utilizează chestiunea aceasta inclusiv pe ambalajele unor produse este o șarlatanie. Un medicament probabil vom avea în câteva luni, un vaccin eficient într-un an, un an și jumătate”, a declarat președintele Societății Române de Microbiologie, pentru Digi24.( Citeste si: Premierul Mark Rutte le cere olandezilor să stea liniştiţi, există suficientă hârtie igienică pentru următorii zece ani- VIDEO)











